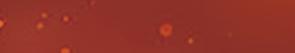

Two years of progress. Southeast TechHub reflects on the past at anniversary celebration.
PAGE A3

Welcome to Estevan. The story behind the latest mural, greeting people upon entrance.
PAGE A5

Thank you for the service!
The Mercury and the community celebrate Police Week.
PAGES A8-9

Latest from the ag sector. Agri News special provides update on upcoming Energy City Ex.
PAGE A10
First grad. Mary’s Little Lambs wish their young graduates farewell in special section.
PAGE A12
WEDNESDAY, MAY 15, 2024
Petition for referendum on downtown revitalization deemed insufficient
 By David Willberg
By David Willberg
There won’t be a public referendum on the downtown revitalization project underway in Estevan.
Estevan city council held a special meeting last Wednesday to discuss a petition sufficiency report, prepared by city clerk Judy Pilloud, in response to the petition that was submitted by the Concerned Citizens Estevan SK group.
Concerned Citizens’ member Greg Curtis submitted the document on April 9, and the city had one month to respond. The petition was scrutinized by the city’s legal team.
Pilloud’s report said the petition had 1,491 signatures lines, which exceeded the 1,085 required for a referendum to occur. It needed to have signatures of at least 10 per cent of citizens; according to the 2021 federal census, the city of Estevan’s population was 10,851 people.
The report went on to say signature entries were excluded for a variety of reasons. A total of 140 addresses were incomplete, incorrect or were not within city limits. Also, 273 entries did not have signature dates which could be confirmed as occurring after March 13, which was the date of the petition’s first signature.

Sixty-two entries did not have a legible, printed name or signature.
One entry, according to the report, had “Estevan” as the signature line, and one had two signatures on one line. Three entries did not have a witness, and five individuals signed the petition twice, for 10 more entries that were excluded.
“Four hundred and eighty-five entries on the petition were determined to be non-compliant with the act [The Cities’ Act] and were excluded in my count,” the report stated.
It left 1,006 eligible entries on the petition, below the 1,085 mark, so council was not required to take further action.
After the meeting, Mayor Ludwig pointed out that even if there was one flaw with the petition, it could have been disqualified.
“If it would have been close, we probably would have asked council what their thoughts were, and council would have made that decision,” said Ludwig.
A referendum would have cost the city more than $60,000, Ludwig said, as the last civic election had a $55,000-$60,000 price tag.
A large crowd attended the late-afternoon meeting, with representatives of the Concerned Citizens and the Estevan Down-

town Business Association present. The meeting occurred while work took place on the undergrounds in the 1200-block of Fourth Street, which is connected to the downtown revitalization.
Other tasks associated with the project occurred before the sufficiency report was released. ASL Paving has been selected as the general contractor, meetings have been taking place and trees along the affected blocks of Fourth Street have been removed. The city has been working on a valve replacement in the 1000-block of Fourth Street, as water valves had to be replaced so they could be closed during the revitalization work.
“Our valves were seized, and we had recognized that, so we had to replace those valves so we could shut the water off,” said Ludwig.
Water main replacement in the 1000-block is not scheduled to occur this year.
Ludwig said the city couldn’t wait for the petition sufficiency report before starting work on the downtown project, due to the tight timelines the city is facing. Any work for the project needs to be completed by March 31, 2025, to be eligible for government funding, and Ludwig pointed out they won’t be
able to do much, if anything, in winter.
“It has to be done by fall to meet the requirements of the federal grant,” said Ludwig.
The Concerned Citizens were slated to appear before council at Monday night’s meeting to discuss the petition and ongoing concerns with the downtown revitalization project, but they weren’t able to attend.
In their place, Michael Walker with Associated Engineering provided a brief update. He told council the project is progressing well.
“We have identified some contamination in multiple areas on the site. We are dealing with that right now,” said Walker.
Ludwig said the contaminated ground was due to a business at the intersection of Fourth Street and 11th Avenue that had gas pumps.
Two-part contracts have been awarded, Walker said, and a couple of local subcontractors have been selected.
“We’ve got all the civil undergrounds in the first part, and the second part, once those prices are coming back, we are going to be working towards that budget, of the approved scope, in the original project,” said Walker. “So, we have to figure out how we fit that in.”

















READ IT ONLINE AT
A large crowd attended a special meeting of Estevan city council last Monday.
A2 » COUNCIL
Mary’s
Little Lambs
Class of 2024
Solar storm brings colorful auroras to the southeast
A series of powerful solar storms treated residents of southeast Saskatchewan, and many other areas in the southern parts of Canada, the U.S., and parts of Europe to magnificent night views on Friday night.
The storms brought in the aurora borealis, or northern lights, which were unusually visible this far south on Friday.
The recent geomagnetic storm resulted in colorful auroras throughout most of the night. Colours beyond green could be seen with the naked eye, allowing many residents of southeast Saskatchewan to experience the living skies.
The aurora borealis, or the northern lights, is a mesmerizing natural phenomenon characterized by vibrant and colorful lights dancing across the night sky, primarily observed in high-latitude regions near Earth’s polar regions, such as the Arctic Circle. The aurora borealis is caused by the interaction of charged particles from the sun with Earth’s magnetosphere.
While auroras can occasionally be visible in southern Saskatchewan during periods of heightened solar activity and favorable geomagnetic conditions, their frequency of occurrence in this region is generally lower compared to more northern latitudes.
The term “aurora borealis” comes from the Latin words “aurora,” meaning “dawn,” and “borealis”, derived from the name of the ancient god of the north wind Boreas, meaning “of the north.” It is named after the Roman goddess of dawn, Aurora, and the northern location where the phenomenon is often observed.
Overall, the aurora borealis is a captivating manifestation of the complex interaction between the sun, Earth’s magnetic field, and the planet’s atmosphere.
By Ana Bykhovskaia SASKTODAY.ca
The new Estevan regional nursing home project is seeing more progress, as the local committee has recently put forward recommendations to the provincial government on how they see the building.
The committee met with representatives of the Saskatchewan Health Authority and the Ministry of Health earlier this year, when the business case for the new nursing home was presented, and the location, building size and cost were discussed. The business plan calls for 167 long-term care beds, and to meet that goal two potential options were suggested.
“We were presented with two options – a greenspace owned by the city, just opposite the hospital across Sister Roddy Road; or [option] two – build on the property of St. Joe’s hospital. The 167 beds indicated in the needs assessment could be made up of the 38 long-term care beds that are presently within St Joe’s special care component of the hospital and add 129 new beds,” said Don Kindopp, the chairman of the new nursing home committee.
The committee was asked to provide their recommendations to the government.
“We discussed the various options that were in front of us. And we rec-

ommended to the government that we proceed with building 129 new beds on the greenspace that is opposite the hospital across Sister Ruddy Road,” Kindopp said.
“The basic reason for that was the space for the building itself. Otherwise building on St. Joe’s property would force us to go higher in stories.
“There are a lot of pros and cons in doing that, but we felt cost-wise and spacewise, that this would be the best, and that St. Joe’s hospital would make every effort to accommodate the care needed within the new construction in terms of visiting a doctor or requiring X-rays or things of that nature.”
He also outlined that within the new building, they are also considering creating an adult day program, palliative and respite care, and they are looking into the potential for a daycare unit for staff and – if there are still any openings afterwards – the community.
The recommendation has been sent to Tim McLeod, Saskatchewan’s Minister of Mental Health and Addictions, Seniors, and Rural and Remote Health, to then go to the cabinet for approval. Kindopp noted that if there are any further questions, the government will reach out to the committee, but otherwise, he expects the next phase, which is the design of the new building, to start soon.
“Once it’s approved by cabinet, they will move into design. And as part of that process, we are hopeful that we will be involved in some of those discussions around design. There is a possibility that by spring of next year, it could be started to have some groundwork done, that’s looking into my crystal ball. And if that crystal ball vision of spring of 2025 is cloudy, then probably the fall of 2025 would be a possibility,” Kindopp said.
However, the work for the community, which in 2015 reached $8 million raised as the city’s 20 per cent share of the original projected cost of $40 million, may soon open up again.
“Because the needs as-
Council receives update on downtown work
When asked by Coun. Travis Frank about the phasing of the project, Walker said they are starting with the 1100-block. Sidewalks are largely open for that block.
“That was working with the Downtown Business Association to leave that sidewalk open as long as possible, and then at some point, we will have to delete that access, but we will be working with them to
make sure that we try to do that with as short of a disruption as possible.” Coun. Shelly Veroba wanted to know if there will be businesses with zero access to customers. Walker responded they have minimized that risk, but there are one or two cases where there is no suitable back access. In those cases, they have been working with the businesses to modify access to get into the businesses



through other means.
“The goal is that at all times, they will have access to the business or place of residence, whether that’s from the front or the back entrance, or we have to modify through an alternate back entrance through, in one case, an interior wall,” said Walker.
Anyone with questions or concerns should contact Associated Engineers.
In a news release issued


last week, the city said the project’s construction will expand to the 1200-block in an estimated five to six weeks. The intersection of Fourth Street and 12th Avenue will remain open as long as possible to assist with traffic flow through the downtown core.
Updates are to be posted on the downtown revitalization section of the city’s website every two weeks throughout the


construction period.
The city has received $7.75 million through the federal government’s Canada Coal Transition Initiative, administered by
sessment indicated 59 more beds than what we had anticipated, the cost will have gone up ... And then the inflation has struck,” said Kindopp.
“The community has a responsibility for a portion of the costs of the new building. And because the number of beds has increased, and certainly inflation’s set up, there will be additional support or funding needed from the community.”
He noted that there is a discussion on how much of a cost should the community be responsible for now that the cost has gone up significantly, but decisions on that and further fundraising efforts haven’t been made.
PrairiesCan, for the revitalization of the 1100 and 1200 blocks of Fourth Street. The city is contributing $1.5 million for the underground work.








« A1 www.SASKTODAY.ca Committee submits their vision for a new nursing home A2 May 15, 2024 Custom Orthotics You Will Walk Better FREE Foot Clinic at Estevan Pharmasave Thursday, May 23 For Appointment Call (306) 637-3802 •Improve Balance and Posture •Be Free of Heel Pain (Plantar Fasciitis) •Relieve Knee, Back, and Hip Pain •Rid Callouses, Straighten Hammer Toes •Ease Burning Feet, Bunions, Numb Toes •Help Foot and Leg Circulation Satisfaction Guaranteed Second Pair of Orthotics only $199.00 Mirran We Are Hiring To Start Immediately: MECHANIC: Employer looking for Journeyman or 3rd or 4th Year Apprentice. Individual required to maintain a large fleet of oilfield trucks and trailers. WELDER: Employer seeking Journeyman Welder. Experience in mig, tig and air arc welding preferred. Competitive wages and health plan. Pre-employment drug and alcohol testing required. 301 Kensington Ave, Estevan, Sk. 306-634-3616 www.bbaxtertransport.ca To Apply email buzz.shirley@bbaxtertransport.ca or fax 306-634-0186 20 Main St. Portal, ND 58772 Mon - Sat 7am-9pm • Sunday 7am-2pm CANTINA Food and Drink Tuesday Night Bingo Saturday Night Canadian’s at Par (food only) Thursday Night $6 Burger & Fries 4pm - 7pm We hold Canadian packages from 1037 5th St • 306.634.5172 • johnsonplumbing.ca GET YOUR SIZZLE ON... with a Gas Grill
Colourful northern lights were observed at Rafferty Dam on Friday night. Photo by Anastasiia Bykhovskaia
Work is underway in the 1200-block of Fourth Street.
By Ana Bykhovskaia SASKTODAY.ca
The Southeast TechHub marked two years of fostering innovation in the region on May 10.
A number of dignitaries and guests joined executive director Gordon More for a lunch celebration at the hub, located on Ninth Avenue.
The event offered a glimpse at achievements and the progress that have been occurred over the past two years.
More, who recently went back to school and enrolled in a program at the Massachusetts Institute of Technology (MIT), said that for him, the visit from former Estevan resident Dr. Eric Grimson, who is chancellor for academic advancement at MIT, was the most influential event TechHub put on.
Among the other highlights of the past two years would be the partnership with the Southeast College, including hosting several Innovation Conversations with notable members of the tech industry; establishing the robot-building, computer science and drone racing clubs in partnership with the local education system; organizing the first local pitch competition; assistance with several startups; and progress on many other projects.
More said the community support has been tremen-
dous throughout these two years, and the interest from people of all ages has been there as well.
“To build a community of innovation ... you have to have the community support. … You need to have the skill set, and you need to have the people who are willing to take some part in innovation, whether they’re funding it or mentoring it, or what have you. It also takes community support to go out into the world and [introduce projects developed locally].
“So I knew when I started here that I needed to create a space for the kids who want to create innovation and be a part of the innovation community. Because as we saw with Eric [Grimson] and Jeff [Sandquist], they had to leave our community. And I think one of the biggest challenges that our community is facing right now is how to [change] it,” More shared.
The event saw addresses from Estevan MLA Lori Carr, Mayor Roy Ludwig, Coun. Rebecca Foord, who is also the chair of the Innovation Council, and Angela Denys with Affinity Credit Union, which is one of the biggest sponsors for the SE TechHub.
“When we started the Innovation Centre two years ago, we truly had the idea of if you build it, they will come. We had our big grand opening. We had this
great day, and then we were like, ‘Now, what’s next?’ … And then we found Gord and we found a lot of what Gord found. We found so many new opportunities through that and so many different people that were interested in innovation,” Foord said.
“I know when people hear the word innovation, they think technology and tech things, [so they think,] ‘I don’t know anything about tech, and I don’t know anything about businesses or how to start a business’. But truly this place is just morphing everything. If you have an idea, if you have a technology idea, if you have a business idea, please just come on down,” she added.
Carr complimented More’s approach to work and thanked him for what he’s been doing for the community.
“When he sees a vision, he really truly goes for it. And it all is in the best interest of our community,” Carr said.
The mayor noted that there are several new projects in the works for the area which make the future for Estevan look exciting.
“For our community, we haven’t done a lot on the innovation side, on the new technology side. And the more we work towards that, the more interesting and exciting it becomes,” Ludwig said.
Denys noted that Tech-

The Estevan Mercury remains the standard by which weekly newspapers are judged in Saskatchewan.
The venerable publication, which was founded in 1903 and remains Estevan’s oldest business, was selected as the best overall paper for Class D – papers with a circulation of at least 6,500 – at this year’s Saskatchewan Weekly Newspaper Association (SWNA) Awards, which were announced Thursday afternoon.
It’s the third time in five years that the Mercury has been named best paper in its division.
The Mercury received a score of 970 out of 1,000 for best overall paper to finish 93 points ahead of the runner-up publication, the Swift Current Southwest Booster.
The Mercury received a perfect score for community news, advertising content, presentation, local features and classified advertising,

and it also received high grades for photography, advertising design and sports.
The Mercury was second for best editorial page, finishing with 90 out of 100 points. It had perfect scores for local content, general content, appearance/grammatical content and its cartoon.
Among the individual awards, David Willberg and Anastasiia Bykhovskaia finished third in the Best News Story category for their coverage of the events on Nov. 1, 2023, in Estevan, in which Justice Guillas killed his mother Karie at their home. When being processed at the police station, Guillas shot and wounded Estevan Police Sgt. Braden Lonsberry. Guillas was then shot by another member of the EPS and died in hospital. Lonsberry returned to work in early December.
“It’s a well-written story with all of the elements and
voices. You also followed the case, over time, which is great. Well done!” wrote the judges.
Bykhovskaia also finished third for the top columnist award.
“Ana Bykhovskaia is an obvious challenger for top spot in years to come,” states the comments from the judges. “Ana has a unique capability of organizing words that, on being read, the reader is made to feel they’ve been speaking with her, much like in a face-toface conversation.
“Her writing is clean, clear, polite, most interesting and is inclusive with all of her community audience. Another shining example of the excellent journalism being published in Saskatchewan.”
Sales manager Christine Jones said she is proud to be part of the Mercury’s team.
“Winning the best allaround newspaper shows the
Hub’s goals align with the credit union’s values.
“The credit union is a company that values innovation, creativity and social impact. We believe that TechHub is a vital asset for the economic development, diversification of Estevan and surrounding areas. The collaboration with entrepreneurs to increase the likelihood of success aligns with our community values. So, we are proud to be a sponsor and to support the transformative work that’s being done daily by the TechHub team,” Denys said.
The day also saw a special address recorded by Estevan expat Jeff Sandquist, a former vice-president at Microsoft, who currently helps run Automattic, which is most notable for WordPress.
dedication and the quality product that our staff works tirelessly to put together,” said Jones. “Although this win may set a standard for which others in our class can aspire to, the other contenders in our class also produce a strong product. The judging in each category cannot be easy.”
Willberg thanked everyone who continues to contribute to the success of the Mercury.
“Best paper is a team award. It takes talented people in editorial and sales, obviously, but it also takes someone in production to lay out the pages. It takes someone in administration to look after the different duties associated with that job. We’re a small team in this office, but everyone knows their responsibilities and we get the job done.
“We also need the people at Estevan Web Printing to print the pages and the car-








“I might live in Carnation, Washington, these days, but my home will always be Estevan,” Sandquist said in his video address.
“Whether you’re young or old, technology is going to be a part of our lives. And one of the most important things to have is communication. And I just think it’s so valuable to have a place like the TechHub where people of all ages can come together and learn more about technology, and more importantly, learn together on how to apply it,” he added.
Guests also heard an update on the portable irrigation project by Wyatt Thompson, who was onehalf of the pitch competition winning team, as well as a presentation of Wild Owl
Orchard – a shippable farm innovative project currently in the works in the area.
The day wrapped up with an address from Tania Andrist, applied research lead officer with the SE College’s Centre of Sustainable Innovation and TechHub’s innovation partner. She reiterated the successful projects brought by the hub and the college, and outlined some exciting new innovative undertakings getting off the ground in the community, such as computer science training through projects, applied research opportunities and more. She also noted that over the past two years, the SE TechHub has become the space where people can come together, learn from each other, and discuss and grow their ideas.
The Mercury wins for best paper at provincial awards
riers to deliver the papers to the community each week.
“We’d like to thank the people of southeast Saskatchewan for not only continuing to read the Mercury each week, but trusting us as your number 1 source for news since 1903. And we’d like to thank the advertisers for continuing to trust with and believing in us, and knowing that the Mercury is a way to reach the public each week.
“You can continue to look forward to seeing the Mercury delivered each week.”




















TechHub celebrates two years of promoting innovations in the southeast
| Wednesday, May 15, 2024 | www.SASKTODAY.ca A3 Get new floor Get new floors right meow. right meow. srs free estimates professional installations WE CAN MRI FOR ESTEVAN IS YOUR BUSINESS PLANNING AN EVENT TO HELP WITH THE FUNDRAISING EFFORTS FOR ST. JOSEPH’S HOSPITAL FOUNDATION MRI FOR ESTEVAN FUNDRAISER? LET THE ESTEVAN MERCURY HELP YOU PROMOTE IT. Your business’ fundraising event ad will be placed on the COMMUNITY PAGE (Page 3) of the Estevan Mercury. The ad size is a 6 column (9.875”) x 3” Banner style ad for the special price of $250.00 (Regular price is $333 -25% Discounted Rate). • Deadline for commitment is the Friday before publication. This special cost will be in effect ONLY for Fundraising Events for the MRI for Estevan. CONTACT YOUR ESTEVAN MERCURY SALES REP FOR MORE INFORMATION (306) 634-2654 IS YOUR BUSINESS HOSTING A FUNDRAISER TO HELP WITH THE MRI? IS YOUR BUSINESS HOSTING A FUNDRAISER TO HELP WITH THE MRI? CHRISTINE JONES, SALES MANAGER cjones@estevanmercury.ca KIM BALL,, SALES REP kball@estevanmercury.ca
COMMUNITY
Estevan expat Jeff Sandquist congratulated the Southeast TechHub and its executive director Gordon More on the second anniversary.
EDITORIAL
Sales Manager
Christine Jones - cjones@glaciermedia.ca
Sales Kim Ball - kball@glaciermedia.ca
Editor David Willberg - dwillberg@glaciermedia.ca
Editorial Staff
Ana Bykhovskaia - abykhovskaia@SASKTODAY.ca
Production Manager
Ana Villarreal - avillarreal@glaciermedia.ca
Production
Laura Kish - lkish@glaciermedia.ca
Administration
Morgan Hodgens - mohodgens@glaciermedia.ca

Referendum petition had to be flawless
Contact us:
(306) 634-2654
68 Souris Avenue N. Estevan, SK S4A 2M3 www.sasktoday.ca
@Estevan_Mercury facebook.com/EstevanMercury
Subscription Rates:
In Saskatchewan - $105 In Canada - $126



Published weekly by Prairie Newspaper Group Limited Partnership, 68 Souris Avenue N., Estevan, SK S4A 2M3. The Estevan Mercury is owned and operated by Prairie Newspaper Group Limited Partnership, a subsidiary of Glacier Media Inc.
Advertising rates are available upon request and are subject to change without notice.
Conditions of editorial and advertising content: The Estevan Mercury attempts to be accurate in Editorial and Advertising content; however, no guarantee is given or implied.The Estevan Mercury reserves the right to revise or reject any or all editorial and advertising content as the newspaper’s principals see fit. The Estevan Mercury will not be responsible for more than one incorrect insertion of an advertisement, and is not responsible for errors in advertisements except for the space occupied by such errors.
The Estevan Mercury will not be responsible for manuscripts, photographs, negatives and other related material that may be submitted for possible publication.
All of the Estevan Mercury’s content is protected by Canadian Copyright laws. Reviews and similar mention of material in this newspaper is granted on the provision thatThe Estevan Mercury receives credit. Otherwise, any reproduction without the permission of the publisher is prohibited. Advertisers purchase space and circulation only. Rights to any advertisement produced by The Estevan Mercury, including artwork, typography, photos, etc., remain the property of this newspaper. Advertisements or parts thereof may not be reproduced or assigned without the consent of the publisher.

The cloud of uncertainty that was hanging over the downtown revitalization project in Estevan appears to have been lifted. There won’t be a referendum taking place on the project. A petition insufficiency report, filed last Wednesday for a special meeting of Estevan city council, revealed that the petition had 1,491 signatures, more than the 1,085 needed for a referendum to be triggered.
But after the city and its legal team combed through each line, it ruled that 485 signatures should be excluded, for a variety of reasons, bringing the document to below 1,085 valid signatures.
Members of the Concerned Citizens Estevan SK group, who launched the petition, were understandably furious, with one person audibly cursing at the meeting after the report was filed. They believe there were enough legitimate signatures for a public vote to proceed.
But you have to think that even if one issue had surfaced, the city would have had enough ammunition to say “sorry, no referendum”.
Long-time residents will remember that in 2008, there was a prolonged debate about residential garbage pickup. Council voted to shift the city to automated, front-yard pickup. The decision caused considerable outcry, and a petition collected more than 2,500 sig-
natures. That petition was rejected as well.
A compromise was eventually reached, with garbage still being picked up in the back alleys, but with automated service using a standardized cart. And, of course, garbage pick-up was moved to front yards a few years later, curbside recycling was finally brought in, and it’s hard to find communities with manual pickup.
There have been a lot of changes since 2008, with a different city administration. Mayor Roy Ludwig is the only holdover from that council. (He was a councillor at the time). But the end result was the same: a petition that called for a referendum on a contentious project was rejected.
It’s not just an Estevan thing. Other communities would do the same thing if they can avoid a referendum.
The lesson of 2008 and 2024 is the same: if you’re going to have a petition that calls for a costly referendum or even a plebiscite, and it’s not going to be held in conjunction with an election, then the petition has to be absolutely flawless. You might think small errors would not be enough to have all of the signatures tossed, but it can be.
If there’s one signature from someone who resides outside of the city limits, one signature from someone not eligible to sign, or one improperly signed line, then that could be enough for all of the signatures to be tossed.
If you’re going to have a petition calling for change or an action, or if you’re voicing frustration, then it won’t be subject to as much scrutiny. But when you’re calling for a public vote outside of an election or by-election, then perfection is the only option. It’s unlikely that we’ve heard the last of the Concerned Citizens on this front. You can be certain they’re going to be monitoring this project closely, and if any issues arise, they’ll be quick to pounce. They still have the right to bring their concerns forward in a respectful fashion.
As for downtown revitalization, it’s going to proceed. We’re going to have a very different-looking downtown core on Fourth Street once this is finished. It’s going to be more attractive, more pedestrian-friendly, and it’s going to encourage people to spend more time downtown. It’s going to be better for visitors.
And the city had to move forward with work on this project while scrutiny of the petition occurred. There’s a limited amount of time to get the work done. While the city has until March 31, 2025, to complete the project, in reality, the work has to be done by this fall, because you won’t see much work happening in the fall or winter.
Will the downtown revitalization enhance economic development and carry the promised benefits? Only time will tell.
From tulips to space dreams, exploring perception and meaning
I’m not a very good visual artist; I’m actually pretty bad, always have been. However, as much as I lack skill, I love delving into any kind of art that comes my way.
My recent artistic attempt took place at the Estevan Public Library during one of their latest painting nights. (By the way, I also tried their paper-making workshop earlier, which was really cool. Check out their program offerings; they have a lot for different ages, and at no cost).
Several guests gathered to be guided through painting tulips. We had all we needed for the painting, thanks to a video. But when you lack talent like me, not only do you need guidance, but you also need someone to stand next to you and correct the mismanaged lines, tilted horizon, wrong proportions, unmatching, not-blending colours, etc. Video guidance, unfortunately, doesn’t allow for it. So, my tulip painting turned out… Well, it didn’t, to my taste. (Please visit SaskToday.ca if you are interested to see how it didn’t turn out.)
Nevertheless, I had a wonderful time and enjoyed every moment of the creative process. (Especially the portion of the workshop when I realized that I screwed up all I could and started painting stars, adding a personal touch to the original idea.)
While having the same paint, brushes and canvas provided, under the same guidance, every participant ended with different results, not only reflecting our skills and talents but also our personality, mood and much more. And even though I didn’t care much about my three funny purple tulips, I felt happier after creating them. I thought it was a great experience, took my painting home, and pretty much forgot all about it. A bit later, when my auntie asked what I was busy with lately, I shared a picture of the

Ana Bykhovskaia Twenty Lines About…
tulips with her. She is a person who always cheers for me, and she said that unlike me, she really liked the result. We had a good laugh about my love for art, and I thought it was the end of the story. But, as it turned out recently, I was wrong.
My auntie is a language and literature teacher, currently working with Grades 5-10, so guess what she did. She tasked her Grade 6 students to write an essay based on my painting. Of course, she didn’t tell them who it was by, nor did she give them a background on it. She just showed them an image and asked to write a brief essay, discussing the potential name and what they see in that painting.
“I’d describe this painting as the Space Dream,” said one of the students. “These flowers are very alive. They look through the dark sky at the stars – at their dreams.”
“I’d name this painting the May Night,” said another student, who visualized herself picking tulips and then enjoying her bouquet laying on the spring field and looking in the sky.
The third student saw the thirst for knowledge in tulips, straining their necks towards the sky, and named the piece Flowers Want to Know Everything.
This curious experience made me think about how reality, perception and meaning work.
The relationship between what we see and the meaning we attribute to it, shaping our perception of reality, is a fascinating in-
terplay of psychology, philosophy and cognitive science. Our perception of not only art but the world, in general, is not a direct reflection of reality but rather a construction of our brains based on sensory input, past experiences, beliefs and cultural influences. The meaning we ascribe to what we perceive is heavily influenced by those factors as well.
(For one kid the picture was about spring, and for the other one it was about knowledge and challenges one faces on the way to it.)
We don’t perceive everything equally, and what we focus on becomes more salient in our perception and can shape our reality. The reality the way we see it is also affected by society we live in. And language plays a separate role in shaping our perception of reality.
After all, what we see and the meaning we prescribe to it are deeply interconnected and mutually reinforcing. Our perception of reality is not a passive reflection of the world but an active and dynamic process shaped by our senses, cognition, experiences and social context.
As odd as it is, this entire experience made me turn to what’s ahead for Estevan.
There are many talks about the future of the Energy City and all of us here now. And while some people state that we are doomed, others see endless opportunities for success. The time will show what we end up with, but I feel that a lot of it will depend on the vision we have, the narrative we tell and the meaning we prescribe to the image of the city, rather than what’s indeed on that painting. (Because, hey, there is a good chance that the anonymous artist didn’t even try putting any meaning into the painting, and it’s up to us to fill it.)
| Wednesday,
15, 2024 | www.SASKTODAY.ca A4 Volume
Staff
May
118 Issue 44 SERVING CANADA’S SUNSHINE CAPITAL
We acknowledge the financial support of the Government of Canada
EDITORIAL
A5
| Wednesday, May 15, 2024 |


New mural a celebration of Estevan
By David Willberg
The latest mural added to the community by artist BJ Zieger is a tribute to Estevan’s attractions and amenities.
The Welcome to Estevan artwork, located on the east side of the Canuckcade building at the intersection of Kensington Avenue and Fourth Street, serves as a greeting to people from outside of the city and also a celebration of some of what Estevan has to offer.
Within the capitalized, block letters of Estevan are a pheasant, the Lignite Louie statue, the city’s water tower with Estevan in quotation marks, a horse, a pump jack with a sunset in the background, agriculture equipment and an Estevan Bruins’ hockey player.
People will also see the sun in the right-hand corner of the mural, paying tribute to Estevan’s status as Canada’s Sunshine Capital, several wheat sheaves; and The Energy City written in stylized letters.
Kevin Mortenson, who owns the building, approached Zieger with the idea of painting the mural.
“I’ve always thought it would look good on the
side of the building there, some sort of a mural,” said Mortenson, who is a neighbour of Zieger’s.
The two work out at the same gym, and when Mortenson approached Zieger, Mortenson described the project as “an old-school postcard” with the lettering. Mortenson gave Zieger an idea of some of the things he wanted, such as Lignite Louie, and let Zieger run with it.
“I’m really impressed with how it turned out. When you come off the overpass, it looks great,” said Mortenson.
He pointed out no taxpayer dollars went into making the project happen.
“I’ve been thinking about this for years, and I had to wait for the people that were renting the building to move out,” said Mortenson. “I decided I should pull the trigger and do this.”
Zieger, who owns the Lucky Buddha Tattoo parlour, is pleased with how the mural turned out. He had a lot of fun creating it and he views the project as a nice way to give back to the community.
“Kevin and I were talking about doing something that represents Estevan,


and I just thought of a few things that I feel like show the town and represent it,” said Zieger.
Lignite Louie is a piece of the city’s history, and pheasants are always around, he said. The Bruins are a big part of Estevan, and farming and the oil sector are important parts of the area’s economy.
Zieger spent about four days working on the project. He said he didn’t mind working on a metal surface.
“Usually I use a mix of brush paint and spray paint, but I couldn’t do that on the metal, so I just used all spray paint,” said Zieger. This isn’t the first mural that Zieger has completed in Estevan, as he has used his artistic talents to enhance the appearance of the city on numerous previous occasions. This won’t be his final project in the community, either, as Zieger said he has some other things in the works.
In addition to greeting visitors, Mortenson also hopes the project will improve morale as people drive into the city. There are some vacant lots where businesses used to be located on the north side of Fourth Street from Kensington Avenue to east of Second Avenue. Mortenson pointed out there is a park and other attractions on the south side of the street.
“I thought it would be
nice to see something nice [when people are] coming into Estevan,” said Mortenson. They have received a lot of favourable comments on social media, and Mortenson is pleased Zieger was able to complete the work.
“The community seems to be behind it,” said Mortenson.
“I’ve had a lot of great compliments about it, and other people seem to like it,” added Zieger.
City of Estevan’s debt continued to drop in 2023
The City of Estevan’s long-term and net debt continued to decrease in 2023, according to audited financial statements released during Monday night’s meeting of Estevan city council.
The document, prepared by the Vitrus Group, shows Estevan’s long-term debt was at $12.23 million at the end of 2023, compared with $13.54 million at the end of 2022.
Net debt, which is the figure the city has em-
phasized for years, was a little more than $8.6 million at the end of last year, compared with more than $11.96 million at the end of the previous year. Net debt is the excess of total liabilities over revenues. Long-term debt accounts for the majority of the city’s liabilities, which were more than $21.64 million at the end of 2023. The city’s assets were $13.04 million.
The biggest share of the city’s assets was $5.36 million in cash and temporary
investments. Taxes receivable were $1.64 million, and other accounts receivable were $1.93 million. Total revenues stood at slightly more than $36 million. Tax revenue was $20.79 million, while fees and charges were at $12.8 million.
Expenses were at $35.1 million. General government costs ($9.03 million) accounted for the largest share, followed by recreation and cultural services ($7.6 million), protective
services ($6.95 million), utility services ($5.46 million) and transportation services ($4.87 million).
The city finished with a surplus of revenues over expenses of $960,941.
Neal Fense with the Vitrus Group appeared before council to speak to members and answer questions. He said there was nothing significant that affected the firm’s approval of the financial statements.
The only error they found was some rate fees
recognized for 2022 should have been listed for 2023. It was discussed with management, the issue has already been addressed, and new processes have been put in place to keep it from happening again.
Coun. Tony Sernick noted some significant variances in revenues and expenses from 2022 to 2023, and wanted to know why. The city had a surplus of nearly $5.73 million two years ago.
Fense responded the city received a lot of mon-
ey through the Canadian Community Building Fund. There was a large surplus that had built up, and so a lot of big projects were completed in 2022.
“Because those projects end up going into the capital assets, and get recognized over time through amortization, that’s why we see that one-year blip.” Other variances were fairly expected and related to different grants and programs that were one-time things, Fense said.
BUSINESS
www.SASKTODAY.ca
This new mural, painted by BJ Zieger, celebrates some of what Estevan has to offer.
Melanie Tribiger Hearing Aid Practitioner Clinic Owner SCH@SunCountryHearing.com 24053GE0
Estevan audience hears inspirational
By Ana Bykhovskaia SASKTODAY.ca
As the community celebrated the outstanding women of the region during the Southeast Women of Distinctions Awards ceremony in Estevan on May 2, Michelle Gilchrist inspired the audience through her speech.
Brooke Spagrud with Southern Plains Co-op introduced Gilchrist as someone whose dedication to leadership and community service exemplifies the spirit of empowerment.
“Michelle’s journey as a leader, professional coach and community volunteer embodies authenticity, resilience and a deep commitment. With over 30 years of experience span-
ning the public and private sectors, Michelle has cultivated a reputation as a transformative force both in professional endeavours and volunteering,” Spagrud said. Gilchrist spoke about self-awareness, people’s values and their role in defining who we are and what we really want. She started her speech by reflecting on the times when she was an eightyear-old marking the first moments of self-awareness.
“It was my first season of self-awareness. Self-awareness around intuition, our built-in mechanism that protects us and guides us if we dare to listen. Selfawareness around connections to grander complexities, the wonder of new
discoveries and being part of something much bigger than myself,” she said.
“Self-awareness around courage and self-confidence and the sheer jubilation of surviving risk. Self-awareness around trust, recognition that in the unyielding patience and encouragement of my big sister, and her ability to hold the fruits of the trust between us, literally in my hand, was the only factor for my willingness to try what seemed to me a certain death.
“Self-awareness is the process that moves us from doing to being. As a human being, self-awareness is crucial. It is the foundation for all relationships. The relationship to self, relationship to community, relationship to others, and

Michelle Gilchrist talked to the Southeast Women of Distinction Awards ceremony’s guests about people’s values and needs.
relationship to society as a whole.”








Report from the Legislature
May 9, 2024
As Saskatchewan’s population and economy continue to grow, our government remains committed to investing in our growing workforce. The 2024-25 provincial budget invests in growing Saskatchewan’s workforce through the advanced education sector, workforce training programs and enhanced credential recognition.
Investing in Saskatchewan’s present and future at the post-secondary education level is a priority for our government. The budget provides $793 million for the Ministry of Advanced Education –an increase of $28.2 million, or 3.7 per cent, from last year – to enhance funding, expand health training programs and focus on key infrastructure projects.
This includes a one-time, $12 million top-up to the province’s current multi-year funding agreement with post-secondary institutions, an increase of 2.2 per cent. The increased funding will allow the institutions to remain responsive to the needs of students and the labour market.
The budget also provides nearly $15 million in new funding to train additional health care workers through the Health Human Resources Action Plan. This includes an operating increase of $11.4 million for new seats across several programs.
Through the Health Human Resources Action Plan, over 610 new seats will be added to training programs for various professions, with a focus on high-demand and hard-to-recruit professions, such as registered nurses, licensed practical nurses, primary care paramedics and continuing care assistants. A total of 600 new seats will be added in nursing programs, including registered nursing, nurse practitioner and registered psychiatric nursing programs. In addition, 32 seats will be added to the undergraduate medical education program.
Our government is also investing $3.6 million this year in new opportunities for students to train in health sciences programs in the province. These include physician assistant, speech language pathology, occupational therapy and respiratory therapy.
Saskatchewan post-secondary institutions receive nearly $725 million in operating and capital grants in this year’s budget. This includes funding to help the Western College of Veterinary Medicine explore an infrastructure expansion. Meanwhile, Indigenous Teacher Education programs will continue to receive funding, supporting the preservation and revitalization of Indigenous languages in the province.
To assist students pursuing post-secondary education, the budget includes $4.2 million in new funding to create a new provincial grant for low-income students with dependents under 12, or over 12 with a permanent disability. This new grant is part of $46.5 million for overall student supports in the budget, which includes $34.4 million for the Student Aid Fund (repayable and scholarships and bursaries.
To help post-secondary students remain in Saskatchewan as they transition to their careers, the budget continues to fund the Graduate Retention Program – the most generous support program of its kind in Canada. The program provides up to $20,000 in tax credits to post-secondary graduates which provides $65 million in support annually.
To help meet current and future labour market needs in our growing province, the Ministry of Immigration and Career Training receives $160.5 million in the budget. This includes continued support for skills training programs and services for unemployed or underemployed persons. These include adult essential skills training, pre-employment programs and services, credentialled skills training programs delivered through post-secondary institutions, and employment for persons with disabilities.
The budget includes an increase of $1.5 million for the Saskatchewan Apprenticeship Trade electrician, plumbing and welding. This increases the investment in apprenticeship training to $22.9 million and expands the number of training seats to 4,700.
To support the Health Human Resources Action Plan, our government will invest in training and settlement supports for in-demand health professions. This includes training seats for continuing care aides, licensed practical nurses and medical lab assistants.
As our government continues investing in Saskatchewan’s workforce, we look forward to hearing your feedback. or loricarrmla@sasktel.net.
Lori Carr, MLA
She noted that selfawareness is needed to understand our core wishes and needs.
“By its very existence, life, and all the messiness and wonder that it presents, offers us a considerable amount of data to sift through and reflect upon to identify what each of us really wants,” she added.
The importance of identifying and honouring personal values was also stressed.
“In every choice we make, every action we take
there are values in play that we are honouring or not. We may not be able to articulate those values, but they are there, and we reap the benefits or pay the price every time we are in or out of alignment with them.”
Gilchrist provided some determinants to identifying our real values, such as paying more attention to things that surround us, including our routine, our shopping habits and more.
“When you identify your core values and align them with your daily activities, you will be able to bring your authentic self to everything you be and do,” Gilchrist said.
The event also saw an insightful presentation by Estevan’s Stacey Wempe, who is releasing her book this fall. Wempe’s Support You Life Coaching and Consulting was the presenting sponsor of the event.
“As people live, bad things happen to good people. And Stacy certainly has had her share. Sudden loss of her 22-year-old brother Clinton. Her mother Margaret died after a short illness in 2009, and her dad
passed away in 2016. But even with all that, Stacey makes the choice to live every day, believes in personal development and seeks to heal and make herself a good and better person,” said Mary Anne Veroba, who MCed the event, when introducing Wempe. Wempe spoke about tragedies she experienced in life, pointing out that every person has difficult events that shape our lives. She noted that there is no right way to happiness, and no matter which way we choose, we often face roadblocks, which are essentially fear.
She spoke about her transformative educational experience, which helped her overcome fear and then pursue a career, in which she now helps others.
Wempe also encouraged the guests to live life today and celebrate achievements.
Wempe’s book A Million Times We Cry is available through Amazon and will see an official release on Sept. 10, on the day when her brother Clint would have turned 50 years old.
Accused in Oxbow woman’s homicide remain in custody
Both men charged after the murder of an Oxbow woman made court appearances recently.
Tyler Japp, 24, of Oxbow, was charged with second-degree murder after the body of Brianna Hayes was found. He had his latest court appearance on May 8 in Carlyle Provincial Court.
Japp’s case was adjourned to May 15 in provincial court in Carlyle.
Tyler Shaw, 27, from Gainsborough, was charged with accessory after the fact to murder in connection to the same homicide. He appeared in Weyburn Provincial Court on May 9,
and was adjourned to be spoken to on June 6 in provincial court in Weyburn.
Both men were remanded into custody.
On April 24, the Carlyle RCMP detachment received a report of a potential homicide. The Saskatchewan RCMP Major Crimes Unit took control of the investigation and began working to confirm this information. As a result of the continued investigation, the body of Hayes was located in a rural location in the RM of Moose Mountain around noon on April 25.
Shaw was arrested and charged the same day, while the second-degree murder charge against Japp was announced on April 26.
Proud to support development of the Lampman Therapeutic Park to increase community access.







www.SASKTODAY.ca
speeches
A6 May 15, 2024
(L-R) Jonathan Kowal, Tundra Oil & Gas, Jay Jones, Mayor of Lampman Lee Ann Karcha, Assistant Administrator, Town of Lampman
306-634-7311 loricarrmla@sasktel.net

The Estevan Wildlife Federation organized a day out on the water to kick off the new fishing season.
Following the official season opening day of May 5, the EWF invited anglers out to Boundary Dam for its Walleye Classic on May 11.
Michael Halirewich, fisheries chairman for the EWF who organizes the event, said with the weather cooperating, they had a good day. Participation was on par with last year with 35 teams competing in the catch-andrelease derby.
“It was a good turnout, lots of new teams, lots of people that have been there for years. So, it’s good to see the familiar faces and new faces as well,” Halirewich said.
Teams came from the Estevan, Regina and Kipling areas, and one travelled from Manitoba.
Delvin and Linda Kushniryk took the top spot in the event, as they weighed in the maximum of six fish, which weighed a total of 20.38 pounds. They also caught the largest fish which weighed six pounds.

Ralph and Nate Smart claimed second spot with a six-fish total weight of 19.2 pounds.
The team of Aaron Toles and Cole Walin came in third, weighing in six fish for a total of 19 pounds.
Rounding out the top six were: Brad Frater and Sheldon McManus, fourth, 18.4 pounds; Rene Sehn and Shane Smith, fifth, 17.02 pounds; and Paul Skoczylas and Jared Patterson, sixth, 16.04 pounds. All participating teams but two weighed in six fish.
The first flight left at 7 a.m., and the second departed 30 minutes later for an eight-hour day of fishing on Boundary. When anglers returned, their haul was weighed and measured not only for competition sakes but also for research purposes.
“We had the University of Regina students who got down again this year. So as the fish were coming in, we’re weighing them and then we’d hand them over to the students and they would do their research studies on them. They take length and weight and then they tag all the fish and then they would return

them to the lake,” Halirewich explained.
Two tagged walleyes were caught during the event, and Halirewich noted that this research is an ongoing process that continues outside the event as well.
“If you catch a tagged fish out on Boundary Dam, there’s a website right on the tag. You just send your
Duncan: No final decision made on potential SMR location
Dustin Duncan, the minister responsible for the Crown Investments Corporation, says there is work to be done before a decision is made on the location of Saskatchewan’s first potential small modular reactor (SMR).
Duncan was asked at a media event on May 7 about a comment during Premier Scott Moe’s speech to the Food Fuel Fertilizer Global Summit in Regina the previous day. Moe said that SaskPower was to place an SMR “quite likely, in the Estevan area — but I don’t think that’s been announced yet.”
The indication from Duncan seemed to be not so fast.
“I would just say the premier’s comments, he certainly is right that Estevan is potentially one of the candidates for the home for Saskatchewan first nuclear reactor and SMR, but there is huge steps that I as a minister have to do along the
way before we can formally make an announcement on that,” said Duncan.
Duncan acknowledged they were still looking at two regions of the province for a potential SMR – the Estevan and Elbow areas.
“The people of those areas have been very enthusiastic about the potential of deploying SMRs in Saskatchewan and they’ve been really great to work with. I know SaskPower has been very complimentary to communities in those recent regions.”
But he noted “there’s a lot of work and due diligence that SaskPower has to do behind the scenes, first and foremost, a very broad consultation with people across the province, as we are putting this question in front of Saskatchewan as to whether or not the generation mix going forward will include nuclear.”
As for when a potential SMR location might be identified, Duncan said
that by this summer, “we’ll be able to be in a position to provide more definitive clarity based on what the premier had said yesterday.”
“And based on again, all the work that’s going on behind the scenes — lots of boxes we need to check in terms of process to get us to a point where we formally make a public announcement. But I would just say that lots of benefits to both regions — that’s why we wanted, why SaskPower wanted to do the due diligence we did to go through the process of establishing
the benefits that would be available at both regions.
“Obviously, Estevan and area has been a very important part of SaskPower’s past and present in terms of generation and transmission and energy for Saskatchewan, and so for both of those reasons there’s lots of benefits for selecting that region. But as I said before, as a minister I still have a few other things on the list of things I have to check off before we can formally make the final decision on which region we would be selecting.”
information in, and they’ll answer you back and tell you when the fish was actually tagged and where it was tagged, and you’ll be able to tell how far it swam and everything,” he added.
After a long day on the water, the participants enjoyed lunch and then were recognized during an award ceremony.

The event is a fundraiser for the EWF and helps them with the maintenance of their facilities, such as the clubhouse and fish-filleting shack at Boundary, Rafferty Marina and more. The EWF also organizes youth summer camps every year and runs other programs, educating about wildlife.










ENERGY | Wednesday, May 15, 2024 | www.SASKTODAY.ca A7 Walleye Classic at Boundary attracts over 30 teams 114 Perkins St, Estevan, SK Phone: (306) 634-3641 Now an Authorized Distributor PHONE BILL at (306) 577-1643 RUBBERSTONE • Cover your ugly concrete with Sierrastone Rubberstone on driveways, sidewalks, basements, decks, garages - 5 year warranty. VU-BA STONE - driveways, sidewalks, garages, decks and basements - 5 year warranty. POLYASPARTIC EPOXY FLAKE in garages and basements. BRICK driveways, firepits, sidewalks, fountains, walls, grain bins, outdoor kitchens. VI-PEQ THERMAL CORK SHIELD - interior and exterior commercial and residential buildings15 years warranty. Goes over tin, wood, brick, stucco, and siding. • Tree and stump removal, cutting & stump grinding. • Industrial and residential hedge trimming. • Farm yard wind row restoration. • Landscaping. • Light carpentry, pergola, gazebos, fences. • Staining fences, decks and steps. • Deck building. • Skidsteer work. • Auger holes (4" to 24"-13" deep) • Screw piles (commercial & residential) CRANES & TRUCKING • All types of hoisting-tip heights to 350’ • 15 – 245 Ton Mobile & R.T. Cranes • 27 – 45 Ton Pickers • 15 Ton Carrydeck - 3.2 Ton Mini Crawler • Tractor Trailer Units • Pile Drivers, Telehandler • Office Trailer Rentals • Manbaskets & Concrete Buckets Serving Southeast Saskatchewan for 38 years www.skyliftservices.com Frontier Place, Estevan 306-634-5555 Apply in person or by email to: SKILLED TRADE EMPLOYMENT OPPORTUNITIES Full - Time Journey Person Electrician & Apprentice Full - Time Journey Person Instrumentation Tech & Apprentice Scott Schoff sschoff.pti@sasktel.net 62 Devonian Street Estevan, SK Ph: 306-637-2180 Fax: 306-637-2180 www.powertech-industries.com GEORGE ANDERSON 306.461.6338 Ande son Hauling Serving Southeast Sask - CUSTOM FLAT DECK HAULING - SNOW REMOVAL/HAUL AWAY - SCRAP IRON REMOVAL - SKID STEER SERVICES -18’TILT TRAILER WITH WINCH (available to rent) - DUMP TRAILER-GOOSE NECK thrutubing.com | 306.634.4001 DRILLING REPORT Drilling Licenses 11 new licenses issued to Monday, May 13, 2024 323997 Crescent Point Energy Hz 4-22-7-9 324662 Vermilion Energy Hz 16-28-4-3 324700 Anova Resources Hz 8-17-4-1 324773 Anova Resources Hz 8-17-4-1 324537 Crescent Point Energy Hz 9-21-5-7 285904 Pemoco Ltd Hz 16-10-9-33 326081 Anova Resources Hz 13-31-4-2 324306 Anova Resources Hz 13-15-8-7 324791 Crescent Point Energy Hz 13-30-40-5 325571 Rok Resources Hz 16-23-2-1 326704 Anova Resources Hz 14-26-3-2 Rig Report 312755 Stampede Drilling Tundra Oil & Gas 3-6-2-15
Students were measuring and marking fish for research before letting them go.
Left, Michael Halirewich with the EWF handed the first-place prize to Delvin and Linda Kushniryk. Photos courtesy of Kendra Lainton















 By David Willberg
By David Willberg
Sgt. Evan Handley and Admin. Sgt. Tyler McMillen have nearly 45 years of combined experience through their time with the Estevan Police Service.
Needless to say, they have seen a lot of changes during that time.
As part of National Police Week in Canada, the two officers reflected on their careers and the changes they have experienced.
Handley has been a member of the Estevan Police Service since November 2003, while McMillen joined in the fall of 2001. Both were promoted to sergeant in September 2015.
For Handley, he always wanted to be a police officer.
“It might sound cliché, but I wanted to help people, and I wanted to make a difference in the community,” Handley recalled. “And this was just something that was always in my mind. It’s something I always wanted to do. I didn’t want to be a firefighter, a doctor, that sort of thing, that wasn’t on my plate.”
Handley had been living in Estevan for some time when he joined the EPS. He already knew some of the long-time members, and he went on some ridealongs before he was hired.
“Every day is different … every time I go to work, something different is going to happen. If I make one traffic stop on a Monday and one on a Tuesday, they’re both different things. Every day when you come in, something new is going to happen. You’re always dealing with different people. It keeps me on
my toes and keeps me from getting bored.”
McMillen, meanwhile, grew up in the Carievale area and always knew he wanted to be a police officer as well, thanks to his interactions with members of the Carnduff RCMP.
He has a hard time believing it’s been nearly a quarter century since his first day on the job.
“You’re so excited when you’re a rookie and getting started. I felt I would have been the rookie for a long time. I felt like I’d be a rookie forever,” said McMillen, who trails only Sgt. Kevin Reed when it comes to consecutive tenure for the EPS.
Const. Craig Bird was on the EPS when McMillen started, but Bird was retired from 2020-2022.
Since his promotion to sergeant, Handley has been in charge of a platoon and he is also in charge of the Combined Traffic Services of Saskatchewan (CTSS) unit, which has two members of the EPS and officers with the RCMP.
“We do projects with them,” Handley said of CTSS. “They help us patrol all over the … southeast corner. So, we do STEP blitzes – Selective Traffic Enforcement Projects … with them, and our members who are there specifically look for traffic-related offences.”
Handley is also part of the Joint Tactical Support Team (JTST), which has officers from Estevan and Weyburn.
When he was still a constable, Handley was working in the major crimes division (now the Criminal Investigations Division).
“I really like patrol. It gives me a chance to work with a small group of people every day. I get to help lead them and help develop their careers, like I was lucky enough, when I was young, to have good sergeants to help develop me and help guide my career on where to go.”
McMillen is one of the officers that Handley cited as someone who helped early on. Reed was another. Gary Eagles, Elmer Vicary, Jerry Michalski, Jay Pierson and others also served as mentors for Handley.
When Handley first started policing, officers were still filling out information on bakers’ cards. Now they have computers and other technology. They care tasers and pepper spray. Radios are more prevalent and are better, and he never thought he’d see the day when in-car computers are used. Tickets are typed instead of handwritten.
“All of the stuff that ... has changed technologywise is amazing to see,” said Handley. “On the other side, [I see] how much safer policing has gotten. When I started for the first couple of years, we didn’t wear bulletproof vests. It’s crazy to think that we didn’t.”
McMillen has seen a lot of those changes during his time, too.
“I did have just the expandable baton. That was kind of new,” said McMillen.
Now they have cameras in police cars, as well as radar that can pick up multiple vehicles at the same time. They use different medical equipment if tending to someone on a trauma-related call. They work more with the

Weyburn Police Service through the JTST.
Investigations have changed thanks to technological evolution.
“You have to send cell phones away and get search warrants for them, and there’s so much data and information to try to extract from them for frauds and drug trafficking and harassments and threats. It’s just changed the game where there’s lots of information on the internet,” said McMillen.
He has also seen the different drugs that have rolled in like fentanyl and methamphetamine, and the negative effects they create for individuals and families.
“Police now are being better trained in identifying the mental health side of things, the addictions, and trying to be part of the solution of trying to find the root cause to get these people the proper services.”
McMillen has gone through another change recently. He recently became the administrative sergeant for the EPS, putting him No. 3 on the command structure behind Chief Rich Lowen and Deputy Chief Warren Morrical. He’ll remain in the post for a four-month trial period.
“It’s been a good experience for the first two weeks to see the gathering of stats and the statistical analysis for the different government agencies,” said McMillen.
He has also had a look at the financial side of things and has been part of the scheduling process. But McMillen said he misses being out in the community, which was part of his duties on the patrol unit.
“I love going through the schools, seeing the kids. That’s where I feed off some energy, seeing those young ones, especially that K-4
[kindergarten to Grade 4] where they’re just kids loving each other,” he said. Teachers have been great to work with whenever he stopped by a school. Handley said Police Week is a good opportunity to recognize police officers everywhere. Oftentimes police gain attention for negative things that happen, so it’s nice to get attention for the positives that officers are doing. Interacting with children and showing them the police car are favourite aspects of the job for Handley.
“We’re at the schools quite regularly,” said Handley. “We’re helping with school patrols. We’re helping do presentations at the schools. There’s lots of things that we do that don’t get publicized, so it’s nice that they recognize the good things that police do in the community, because we do a lot.”
Estevan police arrest man for theft of power
Estevan Police Service members dealt with a number of calls last week, including some thefts, assaults and mental healthrelated issues.
Members attended to a residence for a report of a theft of power on May 11.
A 35-year-old Estevan man was arrested and charged. He will appear in court in July. The same day, police ar-
rested an Estevan woman on outstanding charges of theft and fraud. She was released on an undertaking and will appear in court in June.
Police were dispatched to a business for a reported theft from a donation bin. The matter remains under investigation.
Members were dispatched to a residence for a reported suspicious person.



Several patrols were conducted, but police were not able to locate the subjects of the complaint. The matter is under investigation.
Police also responded to a call for a domestic dispute at a residence in the downtown area. Members spoke with all parties involved and found out that no assault took place. They were able to mediate the situation and the individuals will be referred to the Police and Crisis Team (PACT) for further assistance and supports.
The same day, police were dispatched to a residence for a reported assault. Both parties were intoxicated, and minor injuries were sustained. That matter is still under investigation.
Earlier last week, members received a report of
suspicious individuals at a local hotel on May 6.
Members attended and spoke with hotel staff
Officers responded to a report of a stolen vehicle. The vehicle was taken from south Estevan. The matter is under investigation.
The EPS was dispatched to a report of a driver disobeying school safety patrollers’ directions. A statement was obtained, and the matter is under investigation.
A call was received through the Report Impaired Drivers (RID) line regarding a vehicle travelling in the central part of the city. Members were unable to locate the vehicle.
On May 8, members were dispatched to a business for a man who was not welcome. He was located
and left without any issues.
Police also received a call about a group of youths playing on the railway tracks and rail cars just south of the leisure centre. They were located and warned of their actions.
Police were dispatched to the Pleasantdale area for a report of someone hearing a female who was calling for help. The female was located at a residence and spoken to. No further assistance was needed.
Police arrested a 32-year-old man on May 10 after he was found to be causing a disturbance on Dufferin Avenue. The man was held in custody that night and transported to St. Joseph’s Hospital where he was committed for mental health services.
Police were also called to
a local liquor establishment for a woman in distress. Estevan EMS was dispatched and transported the woman to the hospital. The matter remains under investigation.
Police responded to 76 occurrences over the weekend, including calls for service relating to uttering threats, theft of services, assault, impaired driving and mental health.
Police were called to St. Joseph’s Hospital several times over the weekend to assist and locate mental health patients. A 29-year-old woman was found unconscious by officers in the early morning hours of May 12 along 12th Avenue. Narcan was administered, and the woman was transported by EMS.



www.SASKTODAY.ca Veteran EPS members reflect on their careers
A8 May 15, 2024 POLICE WEEK Thank You FOR YOUR SELFLESS DEDICATION TO HELPING AND PROTECTING OUR COMMUNITIES. Toll free at 1-866-249-4697 www.drrobertkitchen.ca Dr. Robert Kitchen Member of Parliament Souris-Moose Mountain Saluting the police officers in our community! Carnduff, Sk. • (306) 482-3244 POLICE Week May 12-18, 2024 “Committed to Service” THANKS to the POLICE who SERVE and PROTECT our COMMUNITIES with INTEGRITY and RESPECT!
Estevan Police Service Admin. Sgt. Tyler McMillen, left, and Sgt. Evan Handley have seen a lot in their careers.



The recent convention for the Saskatchewan Association of Chiefs of Police (SACP) proved to be an informative time that will help local police with their duties, according to Estevan Deputy Police Chief Warren Morrical.
Morrical and Estevan Police Chief Rich Lowen attended the gathering in Saskatoon on May 9 and 10. It was the first time that Morrical has been at the provincial event since













he was named deputy chief earlier this year, although he has attended previously. After the business session when those present dealt with financial matters, memberships and more, they heard a number of presentations. One was on the mass-stabbing event in September 2022 at the James Smith Cree Nation and the village of Weldon in which Myles Sanderson killed 11 people and injured 18 others. Morrical said the talk
was an opportunity to look back on lessons learned and go through the timeline.
Some of the information could be applied to Estevan.
“It was a good presentation on what occurred and how the RCMP and their partners were able to manage such a large event,” said Morrical.
The lessons are applicable province-wide, Morrical said. An incident of that size requires a complex response, and being able to
Carlyle RCMP investigating truck theft
The Carlyle RCMP is asking for the public’s assistance in locating a truck that was stolen from the Redvers Rink sometime during the evening of May 6. According to a post through the Saskatchewan RCMP’s Crime Watch Advisory Network, the truck is described as a dark green 2014 Ford F-150. The truck has Saskatchewan licence plate

208 JPG and was last seen heading south of Redvers on a gravel road. People can contact the Carlyle RCMP at 306453-6707 if you have any information related to this advisory.

understand both the good decisions and the things that could have been done differently help police to understand what to do if a similar situation unfolds down here.
“I think the biggest thing that they had going for them was the collaboration and partnership with all of the various agencies, and the fact that they were able to respond to so many crime scenes in such a connected, efficient and effective way,” said Morrical.
The next presentation was on civil forfeiture and the opportunities for police and the funding available to law enforcement agencies through that arm of government. Then they heard from the Saskatchewan Firearms Office (SFO) commissioner and deputy commissioner. Former Estevan deputy police chief Murray Cowan moved into the deputy commissioner’s role in April.


The final presentation during the first day was from Walter Natynczyk, a retired Canadian Army general who was the chief of defence staff for the Canadian Forces from 20082012.
“We spent some time with him, learning from what he thinks are the best
practices … for good leaders,” said Morrical.
On the second day, delegates attended a session on collective bargaining agreement negotiations, giving them the same base understanding.
In addition to the chiefs and deputy chiefs for the province’s municipal police services, members of the RCMP, conservation officers and others were in attendance.
Each chance that the SACP has to come together is beneficial to all of the members, Morrical said, because they get the opportunity to meet and discuss ways to improve the safety of all Saskatchewan residents, talk about leadership of organizations responsible for public safety, and look at ways to work together to have one voice when it comes to discussions or interactions with the government.





























www.SASKTODAY.ca Provincial police chiefs convention filled with information that will help local officers May 15, 2024 A9 POLICE Week May 12-18, 2024 “Committed to Service” THANKS to the POLICE who SERVE and PROTECT our COMMUNITIES with INTEGRITY and RESPECT! 445 4 St, Estevan | 306-634-2815 Police Week 84 Hwy 39 East 306-634-5677 306-634-7922 913 - 5TH STREET, ESTEVAN Thank you for all you do May 12-18, 2024 National Police Week Serving SE Sask. Thank you for keeping us safe gencoasphalt.com 306.634.8001 Locally owned & operated HENDERS DRUGS 1220 - 4th Street, Estevan • 306-634-3666 Thank you to the Police Services in our communities. We appreciate you. 1254 7th St. Estevan, SK 306-634-9994 306-634-5555 | www.skyliftservices.com those who keep us safe. Thanking 1129 4 ST, ESTEVAN • (306) 634-7566 WE SALUTE AND SUPPORT OUR LOCAL POLICE SERVICESTHANK YOU! 1176 Nicholson Road | Estevan, SK S4A 0H3 Tel: 306.637.2400 | Fax: 306.637.2490 MAY 14 - 20 POLICE WEEK Thank You For Your Support & Protection.
Deputy Police Chief Warren Morrical


























www.SASKTODAY.ca A10 May 15, 2024 32 Smith Street, Yorkton 306-783-6666 • www.remaxbluechip.ca 2023 Awards of Merit Recipients ROBBY BEAR 306-641-4977 SHANNON DYKE 306-697-7768 LISA KIRKWOOD 306-728-6789 SHAWN PRYHITKA 306-621-9798 ELYCE WILSON 306-621-HOME (4663) MARK ZAWERUCHA 306-641-9406 DARREN BALABERDA 306-621-2515 LINDA MACK 306-421-3883 RHONDA BLANCHETTE 306-461-9791 SCOTT COMFORT 306-338-9632 YURIY DANYLIUK 306 812-7747 DAVID FANNON 306-921-7253 KATHERINE MCDOWELL 306 620-8898 SHELBY OROSZ 306 621-9074 ROLNA PRANKE 306-435-7343 WADE WINDJACK 306-620-6905 MEAGHAN HADUBIAK 306-562-7485 TO ALL OF OUR CLIENTS AND HARD WORKING AGENTS THANK YOU! THANK YOU! TOP OFFICE FOR CLOSED TRANSACTIONS IN CANADA FOR 2023 (small market)
By Ana Bykhovskaia SASKTODAY.ca
The Energy City Ex, one of the brightest and most exciting summer weekends in Estevan, is just around the corner. The last touches are being applied, as the Estevan Exhibition Association (EEA) board is preparing for the June 14-16 weekend.
The three days promise to be packed with action, excitement and entertainment for all ages.
West Coast Amusement will bring the midway to Estevan for three days, and there will also be rodeo action by the KCRA at the exhibition grounds.
“Things are really good. We have a phenomenal team again this year, so things are coming together and shaping up for the three days just packed full of action and excitement,” said EEA board president Crystal Ross.
The weekend will kick off with the SMILE Services parade through town, ending at the exhibition grounds. The parade will be joined by the 2024 Estevan Comprehensive School graduates, whose official graduation ceremony takes place the next day.
Outside the main attractions of the midway and rodeo, the King of the Prairies Open Steer and Heifer Jackpot cattle show will make a return this year on June 15, as will the quilt exhibition at the Estevan Exhibition building throughout the weekend. New this year will be a live demonstration by local quilters, who will also answer questions about the art.
In addition, there will be a big addition that has been in the works for five years, Ross said, and which will occur throughout the weekend.
“Our biggest, newest and most exciting addition … is the ag pavilion. We got the Saskatchewan Cattlemen’s Association on board bringing the cow dome. We’ve got SAASE [Saskatchewan Association of Agricultural Societies and Exhibitions] bringing multiple displays. Ag in the Classroom is going to be there with their green displays and many interactive hands-on activities for young and old to enjoy.
“We’ve got lots of small critters coming, we’re hoping for bunnies and sheep and maybe goats, many different small livestock to be part of the ag pavilion. The Ministry of Agriculture is
bringing a display. And we’re working on quite a few other associations that can, hopefully, partake, give us a really cool learning experience, and let the kids see where their food really comes from and get their hands dirty. So that’s a super huge, awesome, exciting addition that we really anticipate being a huge success,” Ross said.
The pavilion will be in the Wylie-Mitchell building.
Another attraction is the cabaret, slated for Saturday night, with Tyler Lewis headlining.
The beer gardens will operate at the exhibition grounds throughout the weekend. There also will be a lot of food trucks, and the southeast’s Truco Trick Riders are the hired entertainment for Friday and Saturday.
“That’s a huge and really exciting addition too,” Ross said.
She added there are some Father’s Day surprises coming, which will be announced closer to the event.
The Rodeo Queen contest, which is now Miss Rodeo Estevan, is making a return this year as well.
Two young women – Hannah Ferrier, 19, and Desirae Cleveland, 18, are to compete for the title.
“The role of Miss Rodeo Estevan is much like holding a job in the sense that it requires dedication and sacrifice and, of course, some rewards. The goal is for Miss Rodeo Estevan to be a role model to all young ladies, regardless of whether they’re part of the western lifestyle or not. We’re looking for someone who upholds themselves with grit and grace and is also an ambassador for the board of the rodeo, the Estevan Exhibition Association, and the City of Estevan,” said Annetta McDavid, who is organizing the contest this year.

“We’re very lucky; this year both of our contestants are real cowgirls, but also ladies. Their goal is to make rodeo appearances, and also be involved in the community through public speaking, the sport of rodeo and representing the City of Estevan at local events and when they’re wearing their crown, their buckles, their order sashes as well.”
McDavid noted that Miss Rodeo Estevan contestants will do public service in the year following the coronation, participating in many community events, and representing the EEA and the city. When the queen is not available, the princess should represent her instead.
The contestants are to be judged on four components: horsemanship, personality and appearance, public speaking, and 50/50 raffle ticket sales. McDavid noted that both participation and victory come with many benefits.
“It’s a whole year-long commitment if you’re crowned queen or first princess. But the big attraction for the Miss Rodeo Estevan competition is we have a $1,000 scholarship as one of
the main prizes for continuing education, and that continuing education can be at any accredited educational institution,” McDavid said.
“And it’s really super learning. … We have coaches to help them with public speaking, community members who donate their time, and typically want to remain anonymous, they spend individual time coaching the girls with their public speaking and with their horsemanship, running the patterns, and with the attire. We have the whole community behind us, helping them look their best appearance-wise. It’s really a community that
gives and comes together and supports this,” she added.
The public speaking and horsemanship competitions are on June 10 starting at 6 p.m. at the Estevan Exhibition grounds, and all are welcome to attend.
McDavid said they expect last year’s rodeo queen and princesses to be in attendance this year. She noted the new contestants will not be competing and will be solely focused on their role as Miss Rodeo Estevan contenders, and she encouraged the public to support the young women.
“We want to invite the public to come and watch and cheer and support at the fair and the rodeo through the purchase of our 50/50 tickets and our vendors, and we just love to see everyone come out,” McDavid said.
The public can also vote for the people’s choice award during the fair and rodeo until 8 p.m. on June 14.
The queen and the princess are going to be announced on June 15 before the evening rodeo performance at about 4 p.m.
To ensure the entire event is a success, the EEA is calling for more volunteers. Anyone willing to volunteer can reach out to the EEA by emailing them at eea@sasktel.net.
4H KID OF
They are also looking for non-profit organizations which would like to join them and take over some duties. One would be midway patrol, which is a paid position, but there are also other opportunities to help with the event while also promoting the organization.
“We’re looking for other non-profit groups that are willing to maybe team up and help their association as much as you’re going to help our association. We’re always looking for those relationships to build because the non-profit groups in this community are what makes this whole world go round,” Ross said.
She thanked their major midway sponsor SteamEst Industries, major rodeo sponsor GenCo Asphalt and other local businesses that make the event possible.
“Thank you to all of our wonderful sponsors. It wouldn’t happen without them,” Ross said.
She also thanked the board for endless hours of their work.
“The Exhibition Association board is just a phenomenal group of people. They all work countless hours throughout the whole year, and they’re excited to bring the Energy City Ex back to Estevan, in a bigger and better capacity,” Ross said.






“From
I actually qualified for the youth livestock national judging competition at the








Ag pavilion to be added to three days of action and fun at the Energy City Ex AGRI-NEWS | Wednesday, May 15, 2024 | www.SASKTODAY.ca A11 Dr. Robert Kitchen MP Souris-Moose Mountain P 1-866-249-4697 • www.drrobertkitchen.ca FARMING – FAMILY’S HERITAGE AND FUTURE. As the busy spring season begins be diligent and stay safe! S PH: LANE REALTY LANE REALTY Saskatchewan’s Farm & Ranch Specialists™ PH: 306-569-3380 • EMAIL: lanerealtycorp@sasktel.net WITH OVER 40 YEARS IN THE BUSINESS! www.lanerealty.com HANDSWORTH393 ACRES: 95 arable, balance pasture, 316,300 assess., fenced, between Stoughton and Kipling SOLD For all your buying or selling needs contact Jason Beutler PHONE: (306) 569-3380
Nelson Motors 4-H Member of the Month: KATE NIELSEN
MONTH Name: Kate Nielsen Club: Alameda Beef 4-H Club Age: 18 Years in 4-H: Nine Age group: Senior Kate Nielsen has been a 4-H member since she was really young, but it wasn’t until she was about 11 years old that she found her passion for the organization.
This year’s fair and rodeo weekend is to bring all of last year’s excitement and add some more
during the June 14-16 event. File photo presented by
there, it’s just something that’s really driven me and something that I’ve really enjoyed,” said Nielsen. She enjoys helping the younger kids in the club, and sharing her knowledge and passion with the kids, as Nielsen recalls how the older member were mentors for her when she was young. The 4-H livestock judging program has been a real highlight for Nielsen. Last year she went to regionals and provincials.
judging provincials,
Canadian Western Agribition last fall,” she recalled. “I had a lot of fun, I learned a bunch of stuff, and I got to meet lots of new members and lots of different 4-H members from across not only the province but the country.” She has conducted lots of demonstrations, including some for clubs outside the area. Nielsen has met lots of people through 4-H. She has been part of the Regional 4-H Show and Sale, and she’s looking forward to this year’s sale on June 8 in Alameda. And she has been part of the 4-H public speaking competition.
speaking is … a good skill for everyone to have.
think it’s come in handy for me. I’ve done a lot travelling around and doing what I do with the whole 4-H thing, I think it’s come in handy having to speak in front of people or having to speak about our club to other people,”
Nielsen.
hopes
with 4-H once she ages
of the program by judging cattle at the club or regional shows. She would recommend 4-H and the Alameda club to other people because of all it has done for her.
“From
“I think public
I
said
She
to remain involved
out
Mary’s Little Lambs Preschool 2024 Grad
Learning and fun were offered every
day
Another year is coming to an end at Mary’s Little Lambs preschool in Estevan.
The long-running early learning centre, which has programs for three and four-year-olds, is hosting its spring concert and graduation on May 14. Mary Lawrence said the program is a very important part of May, as the children are always so excited to perform the songs teacher Patti Ksenych has taught them throughout the year.
“Mrs. Ksenych plays guitar and sings, and she shares this wonderful musical talent with the children,” said Lawrence. “The children always sing loud, all the parents and grandparents clap even louder, especially when their child comes out to be capped with their special grad hat and receive their diploma.”
The preschool has classes for three and four-year-olds. This year they had 10 three-year-olds, who gathered on Wednesday mornings. Twenty-three kids are age four and ready to graduate.


at Mary’s Little Lambs preschool
They have 12 in the class that meets Tuesday and Thursday mornings, and 11 who come in the afternoon on those same days.
The year will finish with a picnic on May 15 for the threeyear-olds and May 16 for those who are four. Watermelon and freezies will be enjoyed by everyone. Then the children will collect their copy of their Memories to Treasure DVD, which is a compilation of the pictures taken of each class and put to music.
“This is a treasured keepsake of their year at our preschool,” said Lawrence. “All in all, it was a very successful year, both enrollment-wise and with the children we were blessed to have in our program. Mrs. Ksenych knows she will miss all the children going on to kindergarten, but will welcome all those returning to us in the fall.”
While Mary’s Little Lambs’ focus is to prepare children for their upcoming kindergarten year, they also use a lot of play
and creativity in their program. For example, the April theme is space, so the children use their imagination to take a trip through space to the moon in their pretend rocket ship.
In March, they went on a dinosaur bone hunt, and using their imagination is an important part of those activities. Ksenych also makes use of puppets in some learning concepts, and they even offer a beginning French program.
“She uses French Fuzzy Bear, who introduces the children to some basic French phrases, numbers, letters and songs,” Lawrence said.
With spring here and warmer weather, there are many activities and learning concepts held outside. Weather permitting, they have the children involved in things like hunting for emerging insects, learning about plant growth and planting their own bean seeds. The children were so excited to see their bean seeds had sprouted already and each
child will be taking their seedlings home on the last day of school. A track and field day included many outdoor games and races with ribbons for everyone.
Lawrence said the children made great friends during the past year.
“Friendships, we have been told, continue sometimes for years and years,” Lawrence wrote.
“We are so thankful we can offer such a positive preschool experience, an experience where the children learn many skills and concepts that provide them the necessary stepping stone to their all-important kindergarten year.”
They have received a lot of feedback over the years from many kindergarten teachers and other professionals in the school system about their preschool curriculum















































The preschool is looking forward to another good year in 2024-25. They will continue to take registrations through the spring and summer, but the morning classes fill up fast.
“We offer an excellent alternative for the parents who feel they would like more personalized care for their child’s first ‘away from home’ learning experience, and feel a home-based preschool is a better fit than having their child go into the large and rather intimidating school system at the very young age of three or four,” Lawrence said.
The preschool thanked the parents who enrolled their students at Mary’s Little Lambs during the past school year. They know the children are excited to see themselves in the paper, and they know all the parents look forward to seeing this special in the Mercury each year.
“We have also had many parents over the years tell us how thankful they are that their children began their learning journey with our preschool and our program and how impressed they have been with how their children have progressed during their time at our preschool,” said Lawrence.
































































www.SASKTODAY.ca A12 May 15, 2024
Mary’s Little Lambs Class of 2024
CLASSIFIEDS

Patricia Seipp 1957 - 2024
Patti’s family is deeply saddened to announce her sudden passing at home, on May 7, 2024 at the age of 66.
Patti will be forever loved and remembered by her husband Don Seipp; son Ricky Glandon; granddaughter Madison DeclareGlandon; brothers: Chris Billings and Fred (Valerie) Billings; in-laws: Dan (Lorie) Seipp, Jerry (Doni) Seipp, Barb (Lee) Heinz, Anita (Victor) Lowey, Ray (Charlene) Seipp, and Bernie (Kathy) Seipp, as well as numerous nieces and nephews. She was predeceased by her parents: Romeo & Doris Revette and her siblings: Paul Revette, Eddie Revette, Thomas Revette, and Bertha Clairoux; parents-in-law: Gerald & Agnes Seipp.
The Memorial Service for Patti was held on Tuesday, May 14, 2024 at 10:30 a.m. at Hall Funeral Services, Estevan, with Connie Wheeler officiating. Interment followed at Souris Valley Memorial Gardens, after which everyone was invited to a luncheon at the Royal Canadian Legion, Estevan.
Those wishing to pay tribute to Patti via a donation in her memory may do so directly to the Heart & Stroke Foundation of Canada or the Canadian Mental Health Association.
Hall Funeral Services in Estevan provided care to the Seipp familyDustin Hall, Funeral Director, and Zoe Wagner, Student Funeral Director.

Ralph John Schoff 1935-2024
With heavy hearts the family wishes to announce that Ralph Schoff, late of Estevan, SK passed away peacefully on Thursday, May 2,2024 at St. Joseph’s Hospital, Estevan, SK at the age of 88 years. Ralph was preceded in death by his parents, Joseph and Marion Schoff; step-mother Phyllis Schoff; brothers, Joseph, Jacob, Tony and Edward; sisters, Marion Makellky and Kay Clarke; brothers-in-law, Kasmer McKelkie, Robert Makellky, Ken Clarke, Albert Daniels and Bill Schindel; sisters-in-law, Joyce Schoff, Hazel Schoff and Judy Schoff as well as numerous nieces and nephews.
He is survived by his loving wife Yvonne; children, Victor (Charlene) Schoff, Judy (Dwayne) Bidyk and Scott (Jaime) Schoff; children of the heart, Brian (Debra) Muir, Cameron (Carolyn) Muir, Regan Muir and Kirsten (Scott) Marcia; sisters, Irene Daniels and Louise Schindel and sister-in-law Aileen Schoff. Precious memories will remain with his numerous grandchildren, great grandchildren, nieces and nephews.
A Memorial Service was held on Tuesday, May 7, 2024 at 10:00 a.m. at St. Giles Anglican Church, Estevan, SK with the Venerable Wilma Woods presiding. Lunch followed in the church basement.
Those wishing to pay tribute to Ralph via a donation in his memory may do so directly to the St. Joseph’s Hospital Foundation, 1176 Nicholson Rd., Estevan, SK S4A 0H3.
Hall Funeral Services in Estevan is caring for the Schoff family - Deb Heidinger, Funeral Director.

Muriel Joyce Johnson (nee McKersie) January 22, 1931 ~ April 24, 2024
Joyce came into the world on January 22, 1931 a cold wintry day in Estevan, Saskatchewan, the second of 3 children born to Gavin and Bertha (nee Battersby) McKersie. She attended school in Roche Percee and one year at Estevan Collegiate. Growing up on the farm she liked all the animals. When she was very young her mother once found her sleeping at the barn door with a batch of piglets. Winter time found her and friends sliding down the snow banks or skating on the river. Summer was also a fun time with swimming, berry picking, catching gophers or climbing the huge rocks around the farm. She met George after he was discharged from the army and they were married in December of 1947. Their marriage was blessed with four children Linda, Pam, Gene and Heather. Joyce was an active member of the United Church while living in Bienfait. She taught Sunday school, explorer leader, superintendent for many years, UCW member, was on the church board (holding the Treasurer position for 20 years). She was also the Secretary and on the Planning Committee for the World’s Day of Prayer. Joyce was also an active member of the Ladies Auxiliary Legion for over 50 years and received one of their highest awards, a Meritorius Medal. While also living in Bienfait, she served as town alderman and volunteered on many community functions. She also taught preschool skating skills in the winter as Bienfait had an indoor arena. She enjoyed gardening, sewing, knitting, crocheting and camping. She moved to Estevan to be closer to her husband, George, when he was in a special care home, she helped plant flowers in the courtyard at St. Joseph’s Hospital. Even when she lived in the lodge in Gibbons, Alberta she helped with the gardening. She was very active, walking around town and enjoying coffee with her friends. She also found time during all of this to work as a receptionist at a local doctor’s office, worked as a telephone operator (back in the day) and worked in the local hospital. She will be lovingly remembered by her children Linda Mason, Gene Johnson and Heather Gonas (Mike); son inlaw, Tim Sieben; grandchildren Beckey (Randy), Gavin (Trina), Teena, Kevin, Chelsea (Troy), Melanie (Michael), Alexis, Amy (Darrell) and Adam; ten great grandchildren; four great great grandchildren; brother, Walter of Canal Flats, BC; as well as numerous extended family and friends. She was predeceased by her husband George Johnson; parents, Gavin and Bertha; daughter Pam; son in-law Deane; daughter in-law Debbie; and older brother Fred.
Arrangements have been entrusted to the care of Sturgeon Memorial Funeral Chapel, Rebecca St. Amand Funeral Director, Bon Accord, Alberta 780-921-3900.


Delores Chartrand “Dolly” 1949 - 2024
Delores “Dolly” Chartrand passed away suddenly at her home in Torquay, Sask. on May 5, 2024 at the age of 74.
Dolly will be lovingly remembered by her husband Noel; son Tom (Mandy) Massett; grandson Tommy Ray; daughter Nicole Peters (Steve Vokey); grandsons: William, Christopher, and Jayden; daughter Kathleen Lee; grandchildren: Kyle, Jennifer, and Ryan; sisters: Joanna Blondeau and Lucy Faye Blondeau; brother Roger Blondeau; mother-inlaw Lilliane Chartrand; sister-in-law
Mary (Ron) Meyer, niece Danielle Tremblay, nephew Isaac Tremblay; brother-in-law George Chartrand (Nina Trudeau); sister-in-law Yvonne Chartrand, nephew David Funk; sister-in-law Carol Lebrun; sister-in-law Suzanne (Phil) Coward, nephews: Philip, Adam, and David, as well as numerous nieces and nephews. She was predeceased by her parents: James & Josephine Blondeau; grandson Theo Vokey; sister June Blondeau; brothers-in-law: Noel Lebrun and Fred Funk; sister-in-law Angela Hodge. A celebration of Dolly’s life will be held at a later date. If friends so

Maxine Melanson 1937 - 2024
With heavy hearts the family wishes to announce the passing of our dear mother Maxine Melanson, late of Estevan, Sask. She passed away very peacefully on May 5, 2024, at the Estevan Regional Nursing Home, Estevan, Sask. at the age of 87 years. We grieve at mom’s leaving but we are relieved her suffering on earth is over. Mom’s memory will live on forever in our hearts. We will all miss mom dearly. Mom was predeceased by her parents: Earl & Mary Freundl; grandson Jason Stefanski; brothers: Barry Freundl and Louis Freundl; sister Norma Kuntz; sister-in-law Marg Freundl; brothers-in-law: Al Kuntz, Lyle Neal, and Melvin Chamney; mother-in-law and father-in-law: Ida & Ferdinand Melanson, as well as nieces and nephews and special friend Mary Hein. She is survived by her husband Romeo Melanson; son Tim (Ola) Melanson; daughters: Shiela (Abdou) Zanidean, Jackie Speetjens (Scott), Lori (Dennis) Preston, Connie (Danny) Skoropat, and Roselle (Jason) Heleta; sisters: Judy (Jack) Freeborn, Marjorie Chamney, Lenore Neal, and Betty-Lou (Jerry) Briltz; brothers: Gerald (Yvonne) Freundl and Bobby (Lynn) Freundl, and her dear grandchildren, great grandchildren, nieces and nephews. The Prayer Service was held on Friday, May 10, 2024, at 7:00 p.m. at Hall Funeral Services in Estevan, with Connie Wheeler officiating. The Funeral Mass was celebrated on Saturday, May 11, 2024, at 1:00 p.m. at St. John the Baptist Catholic Church in Estevan, with Rev. Thuy Nguyen the Celebrant. A time of fellowship and refreshments followed in the parish hall, after which the Rite of Committal took place at Souris Valley Memorial Gardens.
In lieu of flowers, donations to the Estevan Regional Nursing Home Auxiliary, 1921 Wellock Road, Estevan, SK S4A 2B5 would be appreciated as tokens of remembrance. We would like to extend our heartfelt gratitude for the loving care that mom received from the staff of the Lampman Community Health Centre, Estevan Regional Nursing Home, and Home Care.
Hall Funeral Services in Estevan provided care to the Melanson familyDustin Hall, Funeral Director.








AC MORGAN, AC MUSTANG, DERBY CDC SO1 SUPER OAT PEAS VERY EARLY YELLOW PEA FORAGE PEAS ALSO AVAILABLE POLISH CANOLA & SPRING TRITICALE mastinseeds.com 403-556-2609
in Dolly’s memory may be made directly
Box 1095, Estevan, SK S4A 2H7. Hall Funeral Services in Estevan is caring for Dolly’s family - Dustin
Director. In loving memory of William Leslie Kvamme June 12 1934-May 13 2022 The special years will not return, When we were all together, But with the love inside out hearts, You’ll walk with us forever. Love always Eileen & Family Lovingly Remembered Marvin H. N. Olischefski October 18, 1934 - May 22, 2010 The special years will not return, When we were all together, But with the love inside our hearts, You will walk with us forever. - Love Terry, Brian, and Gaylene In Appreciation To all you fine friends and relatives for your help celebrating my 90th Birthday. “It was wonderful” Judy O for bringing down the carrot cake and tarts, also spending a week with me. Many thanks for th e gifts and flowers, to the many who phoned to share warm wishes, those folks who took me out to dine, and the many cards I received were heart warming. Love to all, Mary Fedyk FORAGE SEED FOR SALE: Organic & conventional: Sweet Clover, Alfalfa, Red Clover, Smooth Brome, Meadow Brome, Crested Wheatgrass, Timothy, etc. Star City, SK. Birch Rose Acres Ltd. 306-921-9942. FULL LINE OF FORAGE SEEDS. Free blending to your needs. Phone Tom Williamson, Pambrun, SK 306-582-7202. Advertisements and statements contained herein are the sole responsibility of the persons or entities that post the advertisement, and the Saskatchewan Weekly Newspaper Association and membership do not make any warranty as to the accuracy, completeness,truthfulness, or reliability of such advertisements. For greater information on advertising conditions, please consult the Association’s Blanket Advertising Conditions on our website at www. swna.com. Find QUALIFIED, LOCAL EMPLOYEES, using the strength of community newspapers! Visit www. swna.com or call 306-649-1405 to find out how! PROVINCE-WIDE CLASSIFIEDS. 49 local community newspapers, distributing to over 450 communities, including 14 cities. Reach over 550,000 readers weekly. Call 306649-1405 or visit www.swna.com for details.
desire, donations
to the Estevan Humane Society,
Hall, Funeral
| Wednesday, May 15, 2024 | www.SASKTODAY.ca A13 FARM SERVICES CAREER OPPORTUNITIES OBITUARIES FOR SALE IN MEMORIAM CARD OF THANKS ANNOUNCEMENTS LAND FOR SALE WANTED HEALTH SEED & FEED OBITUARIES BUSINESS SERVICES Barristers & Solicitors Paul Elash K.C. Aaron Ludwig, B.Sc., LL.B. Genevieve Schrader, B. Mgt., J.D. Gainsborough: Thursday a.m. Carnduff: Thursday p.m. 1312 - 4th Street, Estevan, SK S4A 0X2 P. (306) 634-3631 • F. (306) 634-6901 • www.kohalyelash.com HEAVY EQUIPMENT OPERATORS Motor scrapers, dozers, excavators, rock trucks, packers; wide range of machines. Lots of work all season. Camp/R & B provided. Competitive wages. Valid drivers license req’d. Send resume and work references to: Bryden Construction and Transport Co. Inc. Fax: 306-769-8844 brydenconstruct@ www. brydenconstruction andtransport.ca I am currently PURCHASING single to large blocks of land. NO FEES OR COMMISSIONS Saskatchewan born and raised, I know farming and farmland and can help you every step of the way. Doug Rue, for further information 306-716-2671 saskfarms@shaw.ca www.sellyourfarm land.com FARMLAND WANTED BARLEY *NEW - AB STANDSWELL* SMOOTH AWN, HIGH YIELDING, GRAIN AND FORAGE GREAT LODGING RESISTANCE 1ST NITROGEN USE EFFICIENT CEREAL IN CANADA CERVEZA, ESMA CDC AUSTENSON CDC MAVERICK, SUNDRE WHEAT PINTAIL, FORAGE OR GRAIN OATS AC JUNIPER,
on Sunday, September 29, 2024 Conexus Arts Centre, Regina YOU CAN NOMINATE A DESERVING SENIOR VOLUNTEER WHO CONTRIBUTES TO YOUR COMMUNITY!
must be: - 55+ - Reside in Sask - Be a volunteer in your community Go to SSM website for more information: www.skseniors mechanism.ca OR email ssm@skseniors mechanism.ca OR phone 306-359-9956 Deadline for nominations is June 14, 2024 NOMINATIONS FOR CELEBRATING SENIORS PROVINCIAL VOLUTNEER AWARDS
FLAX
FEED &
1-877-250-5252 HEART & STROKE FOUNDATION OF SASKATCHEWAN Finding answers. For life. Please Support the Canadian Cancer Society Remember Your Loved Ones with a Memorial Tribute in The Mercury Buying or Selling A Vehicle? The Classifieds will get you on the road! Phone today! 306-634-2654
Gala
Nominees
WE BUY DAMAGED GRAIN HEATED... LIGHT BUGS... TOUGH MIXED GRAIN SPRING THRASHED WHEAT... OATS PEAS... BARLEY CANOLA...
“ON FARM PICKUP” WESTCAN
GRAIN

Estevan Heretics host show and shine
The annual show and shine, organized by the Estevan Heretics Motorcycle Club, took place on May 11 at the Black Grasshopper Pub and Eatery in Estevan. The event showcased a variety of motorcycles, as well as some cars and trucks, for attendees to enjoy. A number of residents stopped by to take a closer look at the vehicles on display.
First-ever masquerade a success for humane society
 By Ana Bykhovskaia SASKTODAY.ca
By Ana Bykhovskaia SASKTODAY.ca
The Estevan Humane Society’s latest fundraising experiment turned out to be a success. Nearly 190 people dressed up, and many masked up, to join the EHS’s shelter for its firstever Masquerade Ladies Night Out on May 11 at the Estevan Exhibition Hall.
Shelter board president Tayja Lakusta said the organization sold all tickets, except for one table, and she was happy with the results.
Di
ff
“Everybody’s dressed up so beautifully. It was well received. It’s fun to have a group of just ladies dressing up and have reason to go out,” Lakusta said. The night featured appetizers catered by Eddie Webster’s, as well as entertainment by comedian/ magician Matt Gore and DJ Ruck n Roll. Guests could also partake in a couple of raffles during the night. The event was put together to help the shelter raise some funds for its building renovations.
“[We put it together]
more so to get some money in the bank to do renovations. We’re planning on getting those spearheaded this summer, so it’ll be hopefully new fencing, fixing up our outdoor yards to make more yards for our dogs, and fixing up that area,” Lakusta said, noting that they also wanted to do something fun for the community.
This past winter, the humane society also put in another furnace into the large dog room, so the fundraiser is to help cover that cost as well as some of their day-to-day expenses.
erent in a good way
Nothing in Estevan, Saskatchewan makes people angrier than trains.
Our town is divided by the CPKC Rail tracks and it seems that trains roll through at the most inopportune times. Last week, a train blocked the tracks on Kensington Avenue, and by the time it finally moved, vehicles were lined up, two lanes wide, all the way back to Walmart. Lately, the railway seems to be better at avoiding the peak traffic hours, but people still

hate waiting on trains. It seemed strange, then, that a couple of Mondays ago, people happily lined up and waited for hours for a train to come through town. This was no ordinary train
Tim Pippus of the Estevan Church of Christ
though. It was a steam locomotive built in December 1930.
The Empress, as she is called, was on a celebration tour and it was a once-in-a-lifetime opportunity to see the old

technology on the rails again. People were excited about the steam train because it was different in a good and interesting way. That last line is important. Different is not always good. I know some Christians who are different in ways that just make them seem strange. They use weird churchy language. They draw strange lines in the sand regarding what they will and will not do. Often, they disengage from their community and only as-
sociate with their Christian friends.
While I understand the motivation behind some of these choices, I do not believe that these actions help us. All they do is make us look odd. What if we took God’s call to be different and lived it out in the best way possible? What if you were known for being the kindest person around? Maybe you could be different by being the most forgiving, the most gracious or the leasteasily angered. What if we were known as the most welcoming people in town?
That sort of life would make a difference and it would be attractive rather than repulsive. Jesus said, “A new command I give you: Love one another. As I have loved you, so you must love one another. By this everyone will know that you are my disciples, if you love one another” (John 13:34-35). That would be different in a good way.
Emergency crews respond to vehicle fire at Rafferty
COMING EVENTS
Estevan firefighters responded to a couple of incidents, as well as fire alarms and more last week. At approximately 6:30 p.m. on May 11, crews were dispatched to a vehicle fire near Rafferty Dam. Crews located and extinguished a vehicle that was on fire. No injuries were reported from that
incident, and it’s currently under investigation by the RCMP, said Estevan Fire Chief Rick Davies.
Earlier the same day, firefighters were dis-
patched to a motor vehicle collision involving a motorcycle north of the city. Crews responded and assisted EMS and RCMP at that scene. There was one



injury reported and the incident is under investigation by the RCMP. Fire crews were requested to come and do a carbon monoxide (CO) investigation on a property in central Estevan on May 9 at about 5 p.m. Incident command responded with gas detection equipment and investigated, and it was determined that there were zero readings of CO. Firefighters were dispatched to a commercial fire alarm in northeast Estevan on May 10 at about 6:30 a.m. Crews responded and determined that the alarm was due to cooking, so their assistance was not required.
The same day at about 11 a.m., crews were called to another commercial fire alarm in the central part of the city. While responding, they were updated that the alarm was due to work being done at the property, so crews were stood down.
www.SASKTODAY.ca
A14 May 15, 2024
Close to 200 women partook in the Estevan Humane Society’s first Masquerade on Saturday.
Matt Gore and DJ Ruck n Roll entertained the guests at the masquerade.




Mayor’s Message
Flashback –May 16, 1984
It was Punk Day at the Estevan Junior High in mid-May of 1984. The winners of the costume contest were, from left, Tara Fichter, Grade 9; Jennifer Brosinsky, Grade 8; Sam Peterson, Grade 7; Huey

This is clean sweep week and as well there will be free landfill weekend May 18-20, 2024. Please take advantage of clean sweep week to get your yard ready for summer.







CONSTRUCTION BULLETIN
The City of Estevan is undertaking construction for the Watermain replacement.
The affected area includes First street between Souris Avenue and eighth Avenue, as well as 8th avenue between First street and Valley Street. Property access and parking restrictions are to occur.
This work will commence May 27, 2024 and will take approximately eight (8) weeks to complete (subject to weather)
City of Estevan will perform this work within the current Bylaw regulations and specifications.
Safety
Construction site could be dangerous. If you have children, please ask them to keep a safe distance from the site. We will take every precaution to ensure
public safety, but we need your assistance to constrain the natural curiosity of younger children. Please DO NOT attempt to go close to areas affected.
Theft or Vandalism
If you see any act of vandalism, theft or anyone suspiciously tampering with equipment, signage or barricades, please contact 306-634-1800, or after hours call Police.
Questions and Concerns
The City of Estevan, Engineering Services apologize for any inconveniences that this work may cause. Thank you in advance for your cooperation and patience. If you have any question or concerns, please call at 634-1800 or approach the supervisor or foreman on site.



www.SASKTODAY.ca May 15, 2024 A15 City Hall: 1102 4th Street 8 am to 4:30 pm | (306) 634-1800 Leisure Office: 701 Souris Avenue 8 am to 4:30 pm | (306) 634-1880
Lukye, Grade 8; Ferne Lattery, Grade 7; and Dave Cook, Grade 9.
A16
Tait selected in first round of WHL Draft SPORTS
By David Willberg
Boston Tait is looking forward to the next chapter in his hockey journey.
The Estevan Minor Hockey Association product was selected in the first round, 12th overall, by the Wenatchee Wild in Thursday’s Western Hockey League (WHL) Prospects Draft. The 6’1” defenceman is coming off of a stellar year, as he finished with 30 goals and 16 assists in 24 games while playing for the Estevan TS&M U15 AA Bruins. He added a goal and two assists in two playoff games for Estevan.
Tait said it was “an absolute honour” to be picked by the Wild.
“It’s been a dream of mine to play for a Western Hockey League organization, and I’m really excited to be part of such a high-class organization
like Wenatchee,” Tait said in an interview with the Mercury and SaskToday.
Tait had spoken with the Wild a few times. He filled out a couple of questionnaires and talked to the director of scouting Leigh Mendelson multiple times, including the night before and the day of the draft.
“They said that if you’re around, then we think you could be a player that would fit into our organization and a player that we would be very, very interested in selecting,” said Tait, who spoke with all 22 teams in the league.
Tait has played all of his minor hockey in Estevan. He said he owes everything to his family and to the local minor hockey system.
“They have done so much for me over the years. I’ve been involved with the minor hockey association

Boston
was selected
by
source from the Wenatchee Wild’s Facebook page
since I was four years old. I’ve had so many different coaches that I’m thankful for, and have really turned me into the player I am today. Not just the player, but the person,” he said. He wants to improve his
side-to-side skating and try to be more deceptive with the puck, making it harder for the opposition to guess his next move.
Tait’s selection was also a historical one. He was the first player selected by the
Wild since the franchise relocated from Winnipeg to the city in Washington state last summer.
During the live YouTube broadcast of the draft, Mendelson said the Wild view him as a “cornerstone defenceman”.
“We obviously like the size, the mobility and the ability to play offence, but he can lean on guys when he has to defensively, and we feel he’s a very wellrounded player. In our interactions with him this year, he’s been a very mature young man and great to deal with,” said Mendelson.
It’s also the earliest an Estevan hockey player has been selected in the WHL Draft since Cole Fonstad was picked fifth overall by the Prince Albert Raiders in 2015. Also on Thursday, forward Nathan Gardiner of Gainsborough, who also played for the TS&M AA Bruins last season, was selected in the sixth round, 117th overall, by the Calgary Hitmen. He has spent several years playing in Estevan minor hockey, and finished last season with 19 goals and 42 assists in 26 games, and added two goals and three assists in two postseason games. Both Tait and Gardiner have committed to play U18 AAA hockey with the Regina Pat Canadians next season. Forward Brock MacDougall, who was born in Estevan and spent last season with the HC Edmonton U15 program, was picked in the eighth round, 159th overall, by the Seattle Thunderbirds. He had 31 goals and 21 assists in 33 games last season, and added five goals and two assists in seven postseason games.
Jenna Knibbs secures volleyball scholarship
A talented young volleyball player from Estevan will be playing in the U.S. next season.
Jenna Knibbs, who is currently in Grade 12 at the Estevan Comprehensive School, has committed to play for the George Fox University Bruins, an NCAA Division 3 school located in Newberg, Ore.
An outside hitter, Knibbs cited numerous reasons for selecting the school.
“It was really unexpected for me to go play at George Fox,” Knibbs said in an interview with the Mercury and SaskToday.
“I was always looking for a team that was outside [Saskatchewan], in the States or somewhere else in Canada because I’ve always wanted to go on an adventure outside of home.”
Knibbs had previous
contact with George Fox coach Emily Davis about the school. She was visiting with her grandparents in Oregon when she was invited to visit the campus.
“It was the perfect atmosphere. It felt so much like family. It’s a Christian school and the coach was so nice. I got to sit down with some of the girls.”
Knibbs will be studying biochemistry at George Fox, and she hopes to attend medical school one day.
“The class sizes at George Fox are really small, so I’ll be able to have lots of connections with my profs, and they have a really good lab-to-theory ratio at their school, so I’m really excited for that because I love lots of hands-on labs, and definitely lots of science,” said Knibbs.
She will be just 2 1/2
hours from her grandparents’ home, and her brother James is just a few hours away in B.C.
Athletics are a big part of the school, she said. The women’s volleyball team has done really well in their conference. She has talked with the other incoming first-year players, and she has interacted with other future teammates.
“We had a Zoom call just a few weeks ago to get to know everybody,” said Knibbs.
According to Knibbs, Davis is looking for players who not only want to be on the volleyball team, but want to get to know the other girls and create a tight-knit team.
Knibbs is currently playing for the Regina Cougars club volleyball team, and commutes from Estevan
to Regina to practise. They will be competing at nationals during the Victoria Day long weekend. She has played in Estevan at the school and club level, and has also competed for the Arcola-based Southeast Vipers.
Knibbs has been with the ECS Elecs senior girls’ volleyball team for three years and has been a captain for the past two.
“From when I’ve been really young, I’ve loved my coaches here,” she said. “They definitely taught me the initial tactical skills that I needed to get to where I am today. It’s definitely been a huge supportive environment with all of the coaches at the school.”
Tamara Franklin, in particular, helped Knibbs become the athlete she is today by picking Knibbs to
Estevan badminton player fourth at provincials
A member of the Estevan Comprehensive School’s badminton team finished fourth at the Saskatchewan High Schools Athletic Association’s provincial championship in Nipawin on Saturday.
Dongjun Won represented the school at the tournament. Won had a great start, defeating an athlete out of Moose Jaw Central 2-0 (2114, 21-10) to start the round robin. He then lost 2-0 (21-15, 21-17) to Felix Lin of Saskatoon’s Walter Murray Collegiate, who went on to win the provincial championship, but Won rebounded to win 2-0 (21-17, 21-17) against a player from Englefeld to finish the round robin with a 2-1 record and ad-

vance to the semifinal.
He fell 2-0 (21-9, 21-9) to Michael Yan from Walter Murray, and lost a tight 2-0 (21-19, 21-19) decision to Sebastian Callo of Regina’s Luther College in the bronze medal game. Callo also defeated Won in the final of the regional qualifier the previous weekend.















|
| www.SASKTODAY.ca
Wednesday, May 15, 2024
Tait
11th overall
the Wenatchee Wild. Photo
Dongjun Won represented the Estevan Comprehensive School at badminton provincials. File photo
be on the senior team when Knibbs was in Grade 10.
Once her season with the Cougars is finished, Knibbs looks forward to
playing some beach volleyball, spending a lot of time in the gym and doing what she can to be ready for the upcoming season.
Silent Art Auction Estevan Public Library May 15th - 18th Estevan Public Library 701 Souris Ave. N Estevan, SK S4A 2TI 306-636-1621 or 306-636-1620 estevan@southeastlibrary.ca The Estevan Public Library will be holding a Silent Art Auction this May. Bid on works of art at the library or online. Proceeds from the auction will help fund the library Makerspace and programming Full Art Auction rules are available at the library and online on the library website. estevanlibrary.weebly.com
Jenna Knibbs of Estevan has committed to play for George Fox University in Oregon. Photo courtesy of Tyler Knibbs.










 By David Willberg
By David Willberg
































































































 By David Willberg
By David Willberg

By Ana Bykhovskaia SASKTODAY.ca
By Ana Bykhovskaia SASKTODAY.ca


































